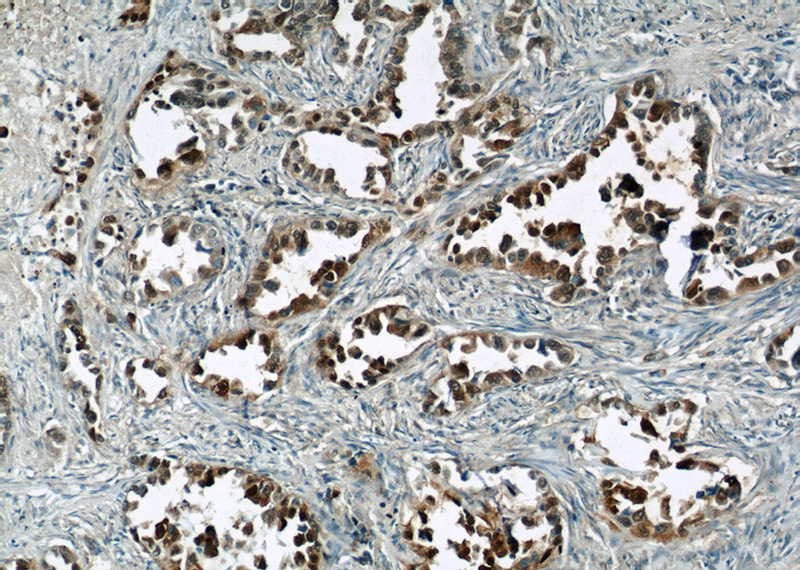
Immunohistochemical of paraffin-embedded human lung cancer using Catalog No:114967(S100P antibody) at dilution of 1:50 (under 10x lens)

-
Product Name
S100P antibody
- Documents
-
Description
S100P Rabbit Polyclonal antibody. Positive FC detected in HepG2 cells. Positive IF detected in HeLa cells, HepG2 cells. Positive IHC detected in human lung cancer tissue, human breast cancer tissue, human lung tissue. Positive WB detected in HeLa cells. Observed molecular weight by Western-blot: 9 kDa
-
Tested applications
ELISA, IHC, WB, FC, IF
-
Species reactivity
Human; other species not tested.
-
Alternative names
MIG9 antibody; Protein S100 E antibody; Protein S100 P antibody; S100 calcium binding protein P antibody; S100E antibody; S100P antibody
-
Isotype
Rabbit IgG
-
Preparation
This antibody was obtained by immunization of S100P recombinant protein (Accession Number: NM_005980). Purification method: Antigen affinity purified.
-
Clonality
Polyclonal
-
Formulation
PBS with 0.1% sodium azide and 50% glycerol pH 7.3.
-
Storage instructions
Store at -20℃. DO NOT ALIQUOT
-
Applications
Recommended Dilution:
WB: 1:500-1:5000
IHC: 1:20-1:200
IF: 1:20-1:200
-
Validations

HeLa cells were subjected to SDS PAGE followed by western blot with Catalog No:114967(S100P antibody) at dilution of 1:1000
Immunohistochemical of paraffin-embedded human lung cancer using Catalog No:114967(S100P antibody) at dilution of 1:50 (under 10x lens)

Immunohistochemical of paraffin-embedded human lung cancer using Catalog No:114967(S100P antibody) at dilution of 1:50 (under 40x lens)

Immunofluorescent analysis of HeLa cells using Catalog No:114967(S100P Antibody) at dilution of 1:50 and Alexa Fluor 488-congugated AffiniPure Goat Anti-Rabbit IgG(H+L)

1X10^6 HepG2 cells were stained with 0.2ug S100P antibody (Catalog No:114967, red) and control antibody (blue). Fixed with 90% MeOH blocked with 3% BSA (30 min). Alexa Fluor 488-congugated AffiniPure Goat Anti-Rabbit IgG(H+L) with dilution 1:1000.
-
Background
S100P protein is a relatively small (95 amino acid) isoform of the S100 protein family that was first isolated from human placenta. Overexpression of S100P has been detected in several cancers such as breast, colon, prostate, pancreatic and lung carcinomas, and the protein has been functionally implicated in carcinogenic processes. S100P protein is widely expressed in both normal and neoplastic tissues. It clearly shows ectopic expression in some cancers. Based on the high expression in certain tumors, S100P could represent a potential target for novel diagnostic and therapeutic applications.
-
References
- F Lam F, Jankova L, Dent OF. Identification of distinctive protein expression patterns in colorectal adenoma. Proteomics. Clinical applications. 4(1):60-70. 2010.
- Jung MJ, Roh JL, Choi SH. Basal cell adenocarcinoma of the salivary gland: a morphological and immunohistochemical comparison with basal cell adenoma with and without capsular invasion. Diagnostic pathology. 8:171. 2013.
- Wang X, Tian T, Li X. High expression of S100P is associated with unfavorable prognosis and tumor progression in patients with epithelial ovarian cancer. American journal of cancer research. 5(8):2409-21. 2015.
Related Products / Services
Please note: All products are "FOR RESEARCH USE ONLY AND ARE NOT INTENDED FOR DIAGNOSTIC OR THERAPEUTIC USE"
